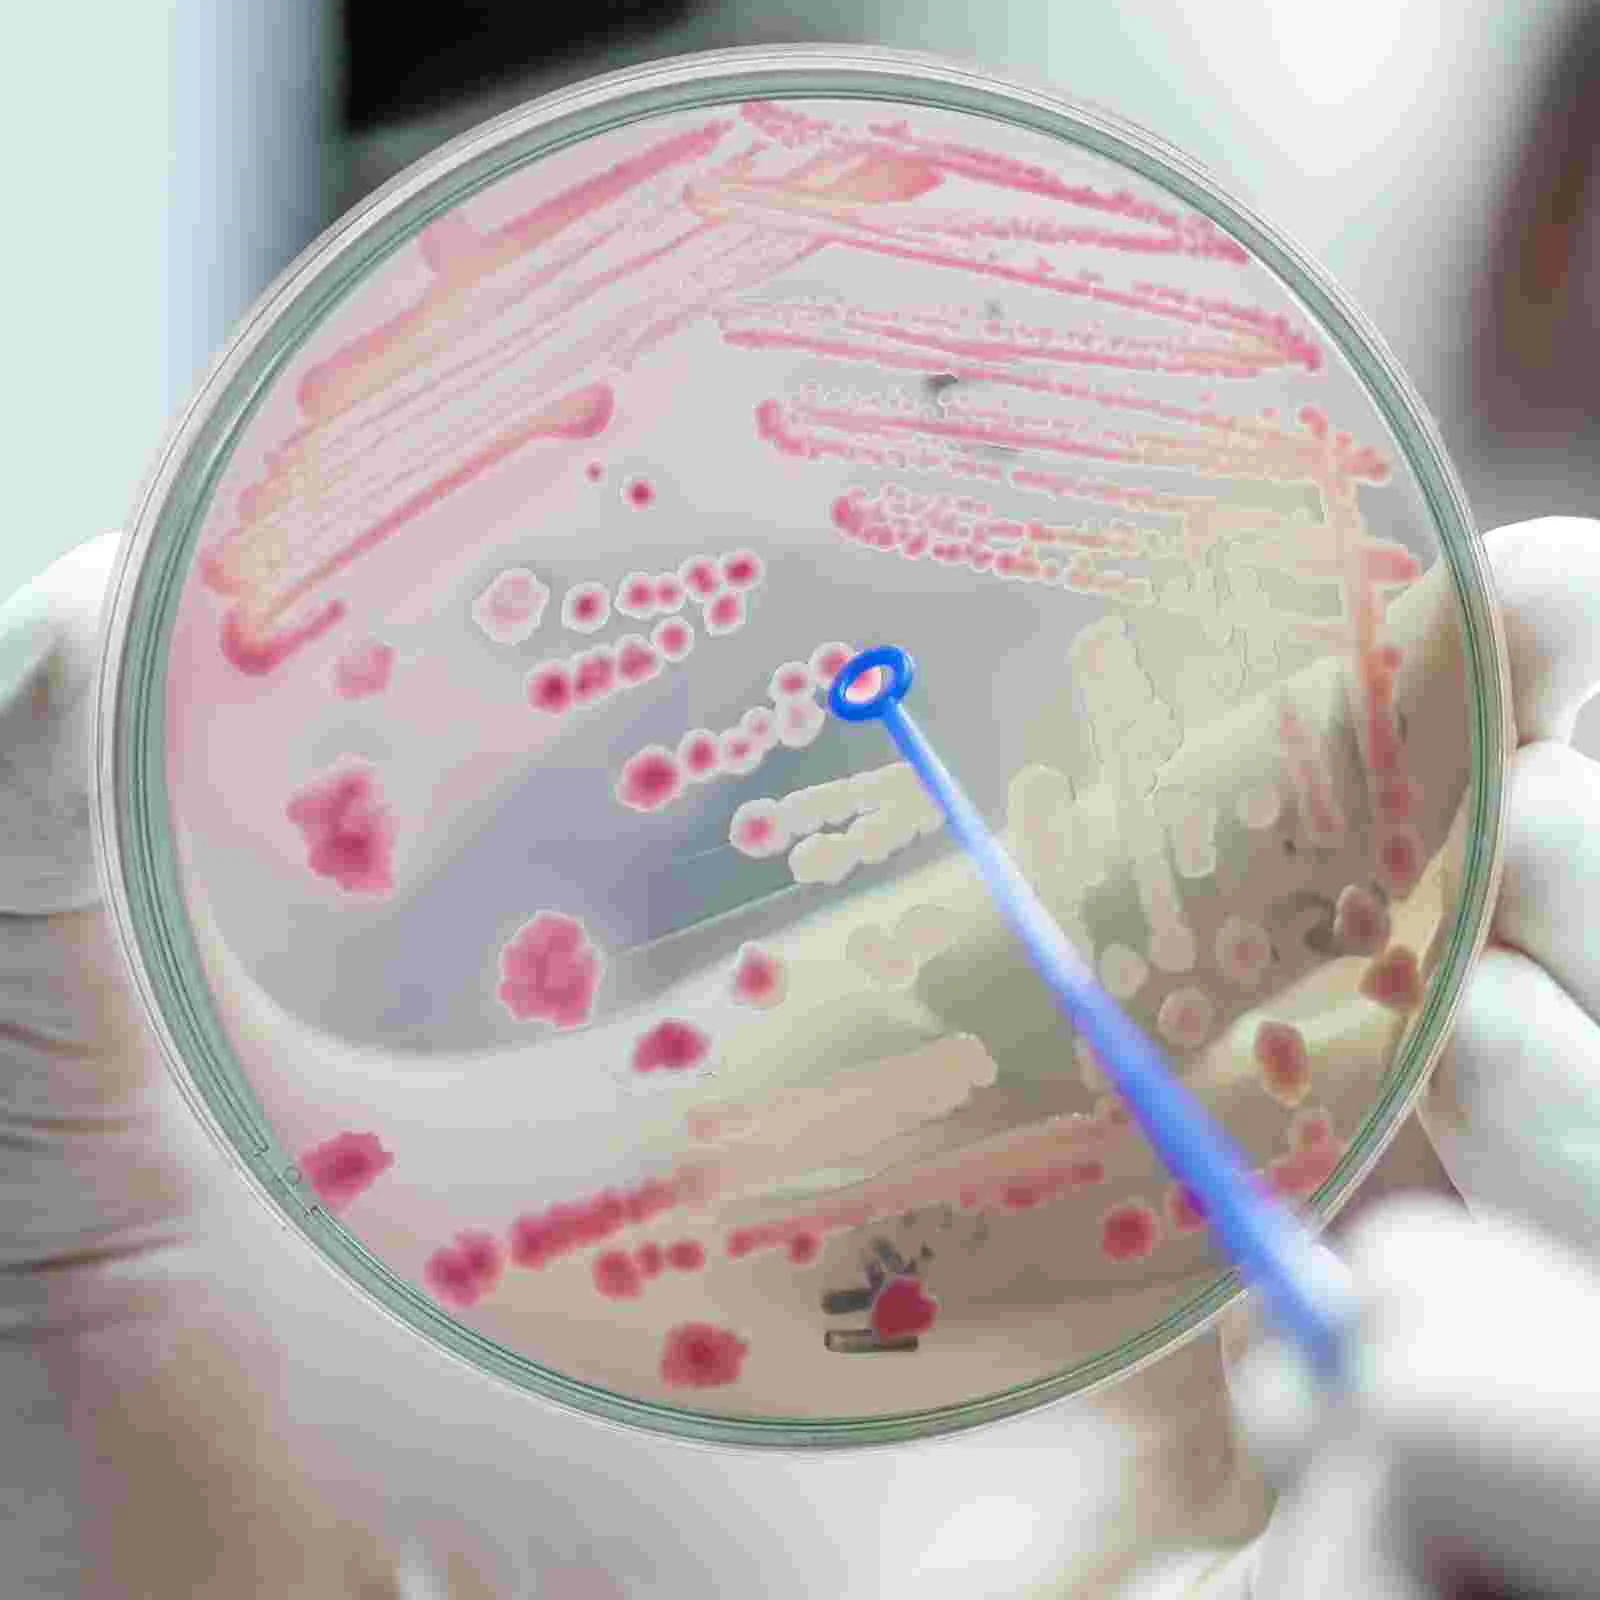
thumb

Тарелки для агара Петри, тарелки для предварительно вылитого агара, тарелки для агаров, лабораторные товары для научных экспериментов
Price history chart & currency exchange rate
Customers also viewed

$44.42
New Genuine Pacha Dog Plush Battery Charger 4500mah Sanrio Cartoon Character Doll Birthday Gift For Boyfriend And Girlfriend
aliexpress.com
$2.42
Набор из 3 предметов «сделай сам», 12,1 мм, зеркальная силиконовая форма, алюминиевое кольцо, кронштейн с одним отверстием, зеркальный инструмент
aliexpress.com
$74.13
10Pcs Car Transmission Solenoid Valve For Citroen Peugeot Renault AL4/DPO 2574.16
aliexpress.com
$116.42
Fashionable leather handbag, new versatile retro bag, light luxury, large capacity single shoulder crossbody bamboo joint bag
aliexpress.com
$4,800.00
Self Service Fozen Food Ice Cream Ice Lolly Vending Machine -18°C Touch Screen Fast Food Popsicle Freezer Vending Machine
aliexpress.com
$4.77
Чехол для Samsung Galaxy A10s с микрофиброй с защитой для камеры чехол на телефон самсунг а10с белый S1Q
bigl.ua
$17.91
2020 New Spring Hoodies Women Harajuku Dinosaur Print Hoodies Retro Cartoon Comic Hoodies Loose Hooded Plus Fleece Pullover
aliexpress.com
$21.36
spring style 0-18 months baby first walkers pure color plaid fashion leisure sports shoes newborn baby shoes toddler shoes wholesale
dhgate.com
$38.34
e shoulder bags round bag women's handbags embossed letter small round bag portable single shoulder messenger women's bag commuter
dhgate.com
$165.98
new men suits cathedral groom wedding dress fashion trim fit one039s morality in europe and the united states business banquet85448163255, Black;gray
dhgate.com
$5.42
9PCS Dart War Theme Birthday Party Decorations For Kids Cool Birthday Party Decoration Supplies Dart War Party Favor For Boys
aliexpress.com
$72.72
krazing pot 2019 natural sheep leather straw made high heel streetwear european simple waterproof dailywear model sandals l10 0928, Black
dhgate.com
$39.85
autumn and winter men's european japanese super fire christmas sweater thick lazy style loose holiday pullover1, White;black
dhgate.com
$20.87
sports embroidered sweater fit stand youth collar solid men's long sleeve cardigan in spring and autumn, Gray
dhgate.com
$28.48
tees male casual loose tshirt mens summer plaid stitching tshirt animal print letter pattern fashion trend, White;black
dhgate.com
$10.23
New Style Children Backpacks 3D Giraffe Design Girls Boys School Bags Toddler Kids Mochila Feminina Kindergarten Cartoon
aliexpress.com
$9.11
Pulley Ratchets Kayak and Canoe Boat Bow and Stern Rope Lock Tie Down Strap 1/8 Inch Duty Adjustable Rope Hanger( 2 PCS)
aliexpress.com
$41.41
400ml Aroma Essential Oil Diffuser Ultrasonic Wood Grain Air Humidifier with 7 Color Changing LED Lights for Office Home
aliexpress.com
$37.63
CosplayANIMECC in Stock XS-3XL Anya Forger Cosplay Costume Wig Anime Movie CODE:White Cosplay Halloween Christmas Outfits for W
aliexpress.com
$37.92
BOCAI S925 Sterling Silver Rings for Men Women New Fashion Twelve Zodiac Guard God Buddha Amulet Jewelry Wholesale
aliexpress.com